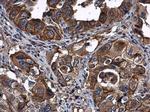
Leptin Receptor Antibody in Immunohistochemistry (Paraffin) (IHC (P))

Search
Invitrogen
Leptin Receptor Polyclonal Antibody
{{$productOrderCtrl.translations['antibody.pdp.commerceCard.promotion.promotions']}}
{{$productOrderCtrl.translations['antibody.pdp.commerceCard.promotion.viewpromo']}}
{{$productOrderCtrl.translations['antibody.pdp.commerceCard.promotion.promocode']}}: {{promo.promoCode}} {{promo.promoTitle}} {{promo.promoDescription}}. {{$productOrderCtrl.translations['antibody.pdp.commerceCard.promotion.learnmore']}}
产品信息
PA5-85621
宿主/亚型
分类
类型
抗原
偶联物
形式
浓度
规格
保存条件
运输条件
RRID
产品详细信息
Keep as concentrated solution.
Predicted reactivity: Dog (86%), Pig (91%), Sheep (86%), Rhesus Monkey (96%), Bovine (86%).
Positive Control: mouse muscle, mouse liver, mouse brain, mouse fetal liver, mouse fetal brain.
Store product as a concentrated solution. Centrifuge briefly prior to opening the vial.
靶标信息
The leptin (OB-R) receptor is a member of the cytokine receptor superfamily which plays an important role in mammalian body weight homeostasis and energy balance. Ligand-induced activation of the OB-R by the adipose tissue-secreted hormone, leptin, appears to activate downstream signaling events through the Janus kinase (JAK)/signal transducer and activator of transcription (STAT) pathway. Leptin can homo-dimerize OB-R extracellular domains while downstream signaling events are initiated upon homo-dimerization of OB-R intracellular domains. Several isoforms of the OB-R which differ in length and signaling capabilities have been reported. RNA transcripts encoding the OB-R long form have been found in the choroid plexus and in the hypothalamus which has been proposed as a control center for satiety and energy expenditure. Mutations in either the mouse OB-R (db) or leptin (ob) genes have been shown to result in early-onset obesity. Metabolic abnormalities attributable to these genotypes include hypercorticoidemia, hyperinsulinemia and insulin resistance, hyperglycemia, altered CNS activity, reduced metabolic rate of brown adipose tissue, and a large increase in white adipose tissue.
仅用于科研。不用于诊断过程。未经明确授权不得转售。